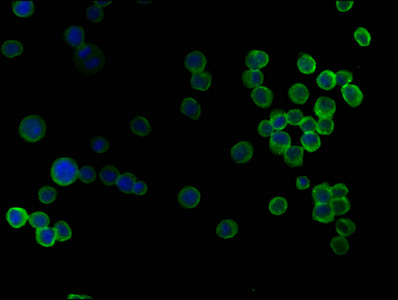
CSB-PA009018PA01HU

SKOR2
SKOR2,全稱為Spermidine/Spermine N1-Acetyltransferase,常見別名包括SAT1和SMNAT1。該蛋白主要參與多胺代謝,通過將精胺和亞精胺轉化為N1-乙酰精胺和N1-乙酰亞精胺,調節細胞內多胺水平,進而影響細胞增殖、凋亡和DNA修復等過程。SKOR2在多種癌癥中表達異常,與腫瘤細胞的生長、轉移和耐藥性密切相關。研究表明,SKOR2的高表達與乳腺癌、前列腺癌、肺癌等惡性腫瘤的發生發展有關,可作為潛在的腫瘤治療靶點。近年來,針對SKOR2的藥物研發取得了一定進展,例如阿斯利康的Truqap(卡匹色替)作為AKT抑制劑,在乳腺癌和前列腺癌的治療中展現出顯著療效。此外,科倫博泰的SKB264作為Trop2 ADC藥物,也在三陰性乳腺癌和非小細胞肺癌的治療中取得了突破性進展。這些研究成果為SKOR2相關信號通路和疾病的治療提供了新的思路和策略。
熱銷產品
SKOR2 Antibody (CSB-PA009018PA01HU)
驗證數據

IHC image of CSB-PA009018PA01HU diluted at 1:100 and staining in paraffin-embedded human prostate cancer performed on a Leica BondTM system. After dewaxing and hydration, antigen retrieval was mediated by high pressure in a citrate buffer (pH 6.0). Section was blocked with 10% normal goat serum 30min at RT. Then primary antibody (1% BSA) was incubated at 4°C overnight. The primary is detected by a biotinylated secondary antibody and visualized using an HRP conjugated SP system.

IHC image of CSB-PA009018PA01HU diluted at 1:100 and staining in paraffin-embedded human colon cancer performed on a Leica BondTM system. After dewaxing and hydration, antigen retrieval was mediated by high pressure in a citrate buffer (pH 6.0). Section was blocked with 10% normal goat serum 30min at RT. Then primary antibody (1% BSA) was incubated at 4°C overnight. The primary is detected by a biotinylated secondary antibody and visualized using an HRP conjugated SP system.
Immunofluorescence staining of K562 cells with CSB-PA009018PA01HU at 1:50, counter-stained with DAPI. The cells were fixed in 4% formaldehyde, permeabilized using 0.2% Triton X-100 and blocked in 10% normal Goat Serum. The cells were then incubated with the antibody overnight at 4°C. The secondary antibody was Alexa Fluor 488-congugated AffiniPure Goat Anti-Rabbit IgG(H+L).
SKOR2 Antibodies
SKOR2 for Homo sapiens (Human)
| 產品貨號 | 產品名稱 | 種屬反應性 | 應用類型 |
|---|---|---|---|
| CSB-PA009018PA01HU | SKOR2 Antibody | Human | ELISA, IHC, IF |
| CSB-PA009018PB01HU | SKOR2 Antibody, HRP conjugated | Human | ELISA |
| CSB-PA009018PD01HU | SKOR2 Antibody, Biotin conjugated | Human | ELISA |
SKOR2 Proteins
SKOR2 Proteins for Homo sapiens (Human)
| 產品貨號 | 產品名稱 | 來源 |
|---|---|---|
| CSB-YP649674HU CSB-EP649674HU CSB-BP649674HU CSB-MP649674HU CSB-EP649674HU-B |
Recombinant Human SKI family transcriptional corepressor 2 (SKOR2), partial | Yeast E.coli Baculovirus Mammalian cell In Vivo Biotinylation in E.coli |













